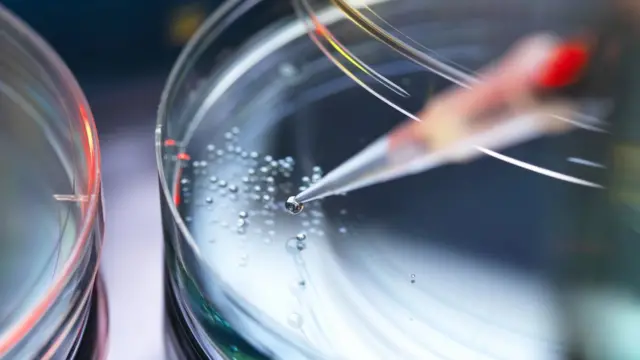
Laboratorio

Por qué identificar el origen de las enfermedades infecciosas es una de las mayores revoluciones de la humanidad

Fuente de la imagen, Getty Images
- Autor, María Blasco Marhuenda
- Título del autor, The Conversation*
- Tiempo de lectura: 6 min
Un hito determinante en el avance de la civilización humana ha sido reconocer que las enfermedades no responden a un origen sobrenatural o son el resultado de "malos aires", sino que tienen un origen tangible y real.
Y que solo conociendo este origen podremos prevenirlas y curarlas.
Un paradigma de este hito han sido las enfermedades infecciosas, pues en este caso el primer paso para combatirlas siempre ha sido conocer su origen, el patógeno que las produce.
El año 2020 pasará a la historia por la pandemia de covid-19, evidenciando que las enfermedades infecciosas no son algo del pasado y que incluso pueden ayudarnos a ser más efectivos en la investigación biomédica.

Fuente de la imagen, Getty Images
Identificar a los patógenos
Robert Koch, médico alemán y padre de la microbiología, estableció la metodología científica para identificar cuáles eran los agentes que causaban las enfermedades infecciosas -también llamadas transmisibles- y así poder combatirlas.
Se trata de los postulados de Koch, que indican que para encontrar el patógeno causante de una enfermedad se tienen que cumplir los siguientes hechos:
- El organismo patógeno debe estar en las personas enfermas y no en las personas sanas.
- Debe ser posible extraerlo de una persona enferma y hacerlo crecer en un laboratorio.
- El organismo patógeno aislado debe ser capaz de reproducir la enfermedad cuando se introduce en personas sanas.
- Las personas infectadas con este patógeno han de desarrollar los mismos síntomas que las personas enfermas de las que se aisló originalmente el patógeno.

Fuente de la imagen, Getty Images
En el caso de la gripe española de 1919-1920, nunca se supo cuál era el agente infeccioso que causaba la enfermedad a pesar de los esfuerzos de unos pocos científicos en EE. UU., Francia y Alemania.
Estos aplicaron los postulados de Koch a cepas de bacterias aisladas de pacientes enfermos que pensaron que podrían ser causantes de la enfermedad.
No era una bacteria
Sin embargo, las bacterias aisladas no cumplieron con los postulados de Koch y, por tanto, hubo que descartarlas como origen de la gripe española.
Al no conocer el germen que producía la gripe española, no se pudieron desarrollar tratamientos efectivos ni vacunas.
La pandemia causó unos 40 millones de muertes en todo el mundo.
Ahora sabemos que el germen causante no era una bacteria, sino un virus, el virus de la gripe A, subtipo H1N1.

Fuente de la imagen, Getty Images
El caso del VIH
Cuando poco más de medio siglo después irrumpió el sida como un extraño cáncer que afectaba a los homosexuales, los científicos Robert Gallo y Luc Montagnier fueron protagonistas de una carrera llena de intrigas para ser los primeros en aislar el patógeno causante de la enfermedad.
Sabían que la única manera de poder controlar la pandemia de sida era encontrar el patógeno que la producía.
Lo consiguió Luc Montagnier y su equipo dos años más tarde, aislando el virus de la inmunodeficiencia humana o VIH.
Hasta entonces, la esperanza de vida de un paciente de sida era de poco más de dos años y los pacientes desarrollaban graves problemas respiratorios y tumores en la piel llamados sarcoma de Kaposi.
Ningún tratamiento dirigido a curar esas patologías conseguía frenar el curso fatal de la enfermedad.
Solo cuando se identificó el virus VIH se consiguió averiguar cómo se transmitía la enfermedad, cómo se podía detectar a las personas infectadas para evitar que lo transmitieran a otras personas.
Pero, sobre todo, permitió que hubiese tratamientos efectivos que hoy salvan la vida a decenas de miles de personas.

Fuente de la imagen, Getty Images
La identificación del SARS-CoV-2
Si en el caso del sida se tardó dos años en averiguar el agente infeccioso que causaba la enfermedad, en el caso de la nueva neumonía de Wuhan (la covid-19) fue una cuestión de semanas.
Científicos chinos, entre los que se encontraba la viróloga del Centro de Virología de Wuhan Shi Zengli, describieron que se trataba de un nuevo coronavirus, el SARS-CoV-2.
Era muy parecido al que causaba la enfermedad SARS y también descubierto por Zengli.
Conocer el patógeno que causaba la covid-19 hizo que de manera casi inmediata se empezaran a probar tratamientos que podían bloquear su entrada en las células o su capacidad de multiplicación.
Apenas unos meses después se estaban probando varias vacunas y no antes de fin de año algunos países ya empezaron a vacunar a grupos vulnerables.
Igualmente se están desarrollando decenas de tratamientos nuevos para bloquear la entrada del virus en las células, para bloquear su capacidad de multiplicación y para tratar los efectos del virus en el organismo.
Sin duda, serán los avances en investigación los que conseguirán que superemos la crisis global producida por este nuevo virus.

No nos equivocamos si afirmamos que el control de las enfermedades infecciosas ha sido la mayor revolución de la humanidad o al menos la que más impacto ha tenido en nuestras vidas y, por ende, en el avance del siglo XX.
La esperanza de vida al nacimiento en Europa era de poco más de treinta años.
Esto era debido a una altísima mortalidad infantil y a que el riesgo de morir era alto en cualquier momento de la vida; una simple infección bacteriana podía hacernos enfermar gravemente y morir.
¿Hasta qué punto podemos aplicar lo que hemos aprendido del control y tratamiento de las enfermedades infecciosas para el tratamiento de otro tipo de enfermedades, muchas de las cuales son hoy incurables?
Las enfermedades no infecciosas
En el siglo XXI, el aumento de riesgo de muerte en los países desarrollados se concentra en las últimas décadas de la vida y está causado fundamentalmente por enfermedades asociadas al proceso de envejecimiento del organismo.
Estas enfermedades incluyen la mayor parte de los cánceres adultos, las enfermedades degenerativas de distintos órganos (pulmón, riñón, hígado, etcétera) y neurodegenerativas, así como las enfermedades cardiovasculares, entre otras.
La incidencia de estas enfermedades está aumentando de una manera muy significativa debido al envejecimiento demográfico de la población.
Por ejemplo, en España en el año 2050 más de un tercio de la población tendrá más de 65 años.
Aunque muchas de estas enfermedades se llevan estudiando durante décadas, aún no se ha conseguido ni prevenirlas ni curarlas con tratamientos efectivos y esto está en contraste con el éxito obtenido con las enfermedades infecciosas.
Muchos investigadores pensamos que el motivo por el que no se ha conseguido controlar estas enfermedades es que se ha ignorado su origen, que en este caso no es un virus o una bacteria, sino el proceso de envejecimiento molecular del organismo.
Fuente de la imagen, Getty Images
Envejecimiento celular
La situación sería análoga a cuando se trataban los tumores de los pacientes con sida, pero la enfermedad seguía progresando y los pacientes morían, pues no se había eliminado el origen, que era el VIH.
Por lo tanto, mientras no se diseñen tratamientos basados en prevención y ralentización o eliminación del proceso de envejecimiento celular, no seremos capaces de prevenir y curar la mayor parte de las enfermedades de la humanidad.
Durante los últimos veinte años se ha averiguado cuáles son algunos de los orígenes moleculares del envejecimiento.
Tambiénse ha demostrado en modelos animales que se puede retrasar el envejecimiento y, con ello, retrasar la aparición de enfermedades asociadas, incluido el cáncer.
De manera análoga a los postulados de Koch para controlar las enfermedades infecciosas, demostrar el origen molecular de una enfermedad no infecciosa sería la única manera de poder prevenirla o curarla.
Hasta cierto punto esto ya ha pasado en el caso del cáncer.

Fuente de la imagen, Getty Images
Actualmente se está tratando a pacientes de cáncer según el origen de su tumor, según el gen o genes alterados en ese tumor particular.
Gracias a esto se está consiguiendo disminuir la mortalidad en muchos tipos de cáncer hasta entonces incurables.
Tratamientos preventivos para bloquear los efectos perniciosos de las mutaciones podrían ser una manera de prevenir los tumores asociados a estas alteraciones.
Medio siglo después
El siguiente paso sería curar enfermedades degenerativas del envejecimiento usando terapias dirigidas a revertir o parar el envejecimiento molecular.
Si estas estrategias tienen éxito, es muy probable que entremos en la siguiente gran revolución de la humanidad.
Y sería análoga a la que se produjo en el siglo XX con el control de las enfermedades infecciosas y que duplicó o triplicó la esperanza de vida al nacimiento.
En esta ocasión, el aumento de la esperanza de vida en buenas condiciones de salud podría ser aún más significativo.
Richard Feynman -nobel de Física en 1965- decía que estamos en el inicio de la evolución de la especie humana.
Sin duda, eso puede cambiar si somos capaces de controlar todas las enfermedades.
*María Blasco Marhuenda es directora del Centro Nacional de Investigaciones Oncológicas, Centro Nacional de Investigaciones Oncológicas CNIO.
Este artículo fue publicado en The Conversation. Puedes leer el original aquí.

Ahora puedes recibir notificaciones de BBC News Mundo. Descarga la nueva versión de nuestra app y actívalas para no perderte nuestro mejor contenido.
Este artículo contiene contenido proporcionado por Google YouTube. Solicitamos tu permiso antes de que algo se cargue, ya que ese sitio puede estar usando cookies y otras tecnologías. Es posible que quieras leer política de cookies y política de privacidad de Google YouTube antes de aceptar. Para ver este contenido, selecciona 'aceptar y continuar'.
Fin del contenido de YouTube











